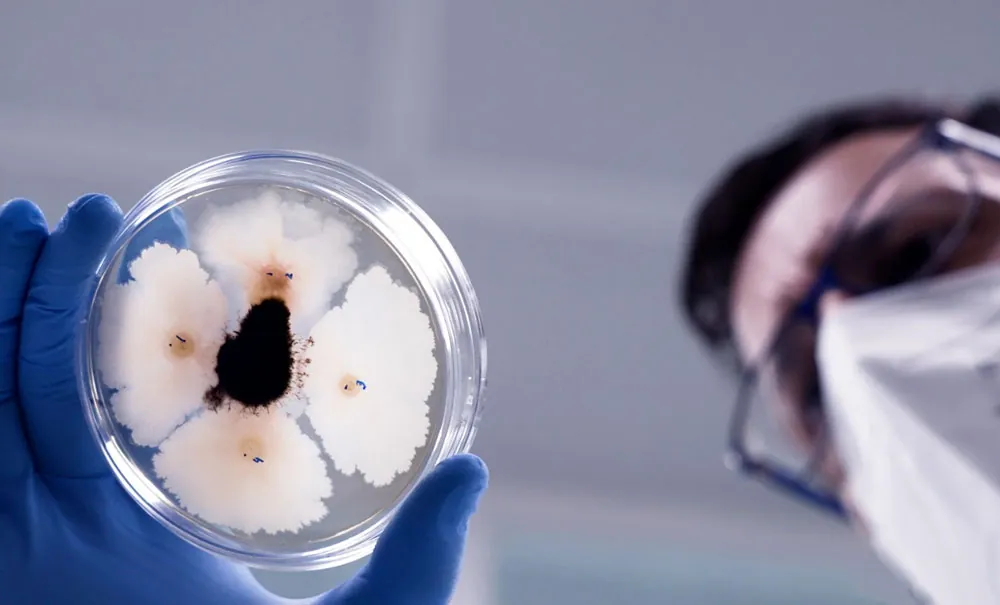
Activos biológicos previamente caracterizados

La agricultura actual se enfrenta a una combinación de retos de enorme complejidad: el impacto del cambio climático, la aparición de nuevas enfermedades, la necesidad de incrementar los rendimientos de forma sostenible y un entorno regulatorio cada vez más restrictivo en el uso de determinados insumos. La magnitud de estos desafíos exige respuestas ágiles y eficaces por parte de los departamentos de I+D+i del sector agrobiotecnológico.
En este contexto, la capacidad de innovación ya no depende únicamente de reaccionar rápido, sino de contar con los activos adecuados para hacerlo. Disponer de una base sólida de investigación básica permite construir una auténtica “biblioteca” de activos biológicos previamente caracterizados, que facilitan la selección y el diseño de prototipos innovadores adaptados a cada necesidad agronómica. Este enfoque es clave para reducir los tiempos de desarrollo y acelerar la llegada de soluciones eficaces al campo.
Sin embargo, uno de los principales malentendidos en el ámbito industrial (también en el sector agrícola), es considerar la investigación básica como una actividad sin retorno inmediato o como un ejercicio meramente académico. Lejos de esa percepción, la investigación básica constituye el punto de partida imprescindible para una investigación aplicada eficiente: evita comenzar de cero, optimiza el uso de recursos y permite desarrollar soluciones con mayores probabilidades de éxito comercial mediante un método de trabajo riguroso y bien estructurado.

Antonio Bernal Soro y la plataforma global de innovación en biotecnología.
Para profundizar en el papel estratégico de la transferencia tecnológica a partir de la investigación básica, entrevistamos a Antonio Bernal Soro, Chief R&D Officer de Agronova Biotech, una plataforma global de innovación en biotecnología agrícola especializada en el desarrollo de soluciones de alto valor añadido a partir de un enfoque científico riguroso, integrado y claramente orientado al mercado.
Desde su posición, Antonio Bernal lidera las estrategias globales de I+D+i de la compañía, abarcando todo el proceso de innovación: desde la investigación básica y la generación de activos biológicos hasta su validación, escalado y conversión en soluciones eficaces y aplicables en campo. Su labor resulta clave para asegurar que el conocimiento científico se traduzca en tecnologías diferenciales, alineadas con las necesidades reales de agricultores, distribuidores y sistemas productivos a nivel internacional.
Con una sólida base técnica y científica y una visión estratégica de la innovación, el departamento de i+D de Agronova Biotech actúa como nexo entre la ciencia y el mercado, impulsando modelos de desarrollo basados en la eficiencia, la escalabilidad y el impacto agronómico real. Este enfoque refuerza el posicionamiento de la empresa como un referente en transferencia tecnológica, capaz de conectar investigación avanzada, desarrollo industrial y aplicación práctica dentro del ecosistema agrobiotecnológico.
Agronova Biotech es una plataforma integral de biotecnología agrícola que incorpora, bajo un enfoque estratégico y de sostenibilidad, a empresas especializadas como Probelte, firma asociada a AEFA.
¿Qué importancia tiene la investigación básica en las empresas del sector agrobiotecnológico?
La investigación básica desempeña un papel fundamental, especialmente en sectores de rápido desarrollo como el agrobiotecnológico. Los desafíos que surgen en el campo, como la aparición de nuevas enfermedades, el impacto del cambio climático o la evolución de los marcos regulatorios, avanzan a gran velocidad, mientras que el proceso necesario para convertir una idea en una solución viable es largo y complejo, desde la investigación inicial y el desarrollo de prototipos hasta los ensayos en campo y los procesos de registro.
Por este motivo, resulta imprescindible contar con una base sólida en la “I” de la I+D. Cuando esta fase inicial no está suficientemente reforzada, se generan cuellos de botella que condicionan todo el desarrollo posterior y retrasan de forma significativa la llegada de soluciones al mercado. Apostar por la investigación básica permite anticiparse a los retos futuros, generando conocimiento, activos biológicos y criterios de selección que facilitan una respuesta más ágil y eficaz cuando surge una necesidad concreta.
Además, la investigación básica es clave para comprender en profundidad los modos de acción de las sustancias activas y de los microorganismos con los que se trabaja. Este conocimiento no solo garantiza un uso más preciso y eficiente en campo, sino que también abre la puerta a identificar nuevas funcionalidades y aplicaciones en activos ya conocidos. En este sentido, la investigación básica se convierte en una herramienta estratégica para maximizar el valor del conocimiento acumulado, optimizar recursos y generar innovación real con una base científica sólida y orientada a su transferencia efectiva.

En este contexto, está la figura del «cepario». ¿Qué valor real tiene que una empresa tenga su propia colección de cultivos? ¿Es un activo estático o una herramienta dinámica?
Podemos afirmar que un «cepario» (Strain bank) es una herramienta estratégica para las empresas y es único para cada una de ellas. Por poner nombres concretos y el valor que se le otorga a modo de ejemplo, contamos con nuestro Agronova Strain Bank y es una herramienta estratégica que sustenta todo nuestro enfoque de innovación.
Se trata de una plataforma construida a partir del aislamiento, la identificación y la caracterización exhaustiva de microorganismos procedentes de una amplia diversidad de suelos y ecosistemas, concebida no como un repositorio estático, sino como una base activa de conocimiento al servicio del desarrollo de soluciones biotecnológicas.
Para ello, contamos con un equipo altamente especializado dedicado de forma exclusiva a estas actividades, que cubre todo el proceso desde el aislamiento inicial hasta la identificación molecular mediante técnicas avanzadas de secuenciación realizadas íntegramente in-house, incluidas tecnologías de lectura larga. Esta capacidad nos permite generar conocimiento propio con agilidad, profundidad y un elevado nivel de control técnico sobre cada etapa del proceso.
¿Qué procesos se siguen con estos microorganismos?
Una vez identificados, los microorganismos, son sometidos a una caracterización integral, tanto desde el punto de vista funcional como de seguridad, lo que nos permite anticiparnos a los requisitos regulatorios que condicionan el desarrollo de este tipo de soluciones.
A nivel funcional, evaluamos de forma sistemática capacidades como la fijación de nitrógeno, la solubilización de nutrientes, la producción de compuestos bioestimulantes con efecto directo sobre la planta y su potencial como agentes de biocontrol, tanto en ensayos in vitro como en planta.
Asimismo, analizamos la interacción de estos microorganismos con el microbioma del suelo, evaluando su comportamiento en combinación con otros microorganismos y estudiando posibles efectos sinérgicos. Para ello, medimos parámetros como la actividad enzimática del suelo y la evolución global del microbioma tras su aplicación, lo que nos permite comprender su impacto en sistemas agronómicos complejos y no únicamente en condiciones controladas.
Toda esta información se integra en una base de datos propia, que convierte el cepario en una plataforma viva de conocimiento. Gracias a esta estructura, cuando surge un nuevo reto agronómico o una oportunidad de aplicación, podemos seleccionar de forma rápida y fundamentada los candidatos más adecuados, reduciendo de manera significativa los tiempos de desarrollo y aumentando las probabilidades de éxito en las fases posteriores de validación y transferencia.

Desde un punto de vista de proceso de bioprospección ¿Cómo se buscan esas cepas en la naturaleza para luego materializarlo en producto?
El proceso de bioprospección comienza en campo. Siguiendo con el ejemplo de nuestra empresa, a través de nuestro propio equipo de técnicos especializados, recoge muestras de suelo y otros matrices ambientales procedentes de distintos ecosistemas. Trabajamos con suelos que presentan características físico-químicas muy diversas, así como con muestras de aguas, lo que nos permite maximizar la diversidad microbiana desde el origen.
Estas muestras se trasladan posteriormente a nuestros laboratorios centrales, donde el equipo de microbiología lleva a cabo el aislamiento, la identificación y la caracterización inicial de los microorganismos con fines tanto taxonómicos como de investigación.
En paralelo, nuestro equipo de fitopatología evalúa las posibles actividades de biocontrol de las cepas aisladas, así como sus capacidades biofertilizantes, mediante ensayos específicos diseñados para detectar su potencial agronómico real.
Un aspecto clave del proceso es la evaluación del perfil de seguridad de cada microorganismo. Para ello, realizamos su identificación y secuenciación completa del genoma, lo que nos permite conocer en profundidad sus características genéticas y anticipar posibles funcionalidades o riesgos desde fases muy tempranas del desarrollo.
Todos estos microorganismos pasan a formar parte de nuestro «cepario» (Agronova Strain bank), pero solo tras varios años de ensayos y validaciones, aquellos que demuestran un perfil sólido desde el punto de vista funcional, de seguridad y de aplicabilidad, son seleccionados como candidatos para el desarrollo de prototipos con funcionalidades concretas.
Desde la perspectiva de descubrimiento de nuevas especies y la tecnología de análisis. ¿Qué importancia tiene hoy la caracterización de cepas a través de técnicas de secuenciación y predicción de genes?
Las técnicas de secuenciación y caracterización avanzada son hoy absolutamente clave, especialmente en un contexto marcado por continuas novedades legislativas tanto a nivel español como europeo. En este contexto, la secuenciación del genoma completo juega un papel fundamental en la correcta asignación taxonómica de los microorganismos, un aspecto crítico desde el punto de vista regulatorio y científico.
Más allá de la taxonomía, la anotación funcional de los genes nos permite predecir, desde fases muy tempranas, las potenciales funcionalidades que un microorganismo puede presentar desde un enfoque agrobiotecnológico. Este conocimiento anticipado resulta esencial para orientar los desarrollos hacia aplicaciones concretas y optimizar los recursos de I+D.
Además, la información genómica es una herramienta clave para evaluar el perfil de seguridad de los microorganismos, permitiendo identificar posibles riesgos y adelantarnos a los requerimientos regulatorios futuros. En conjunto, este enfoque nos proporciona una visión mucho más completa y predictiva, facilitando el descubrimiento de potencialidades que, de otro modo, serían difíciles o imposibles de detectar únicamente mediante ensayos tradicionales.

Este trabajo requiere de una importante especialización y profesionalización en la materia. ¿Cuál es el rol de los profesionales que configuran el equipo en todo este proceso?
Todo este proceso solo es posible gracias a un equipo humano altamente especializado y globalmente coordinado. Para contestualizar la realidad de esta afirmación, pongo como ejemplo nuestra empresa. En la actualidad, Agronova Biotech cuenta con más de 30 profesionales directamente involucrados en actividades de I+D, distribuidos en cinco laboratorios estratégicamente ubicados en España, Portugal y Estados Unidos, lo que nos permite combinar talento local con perspectiva internacional y acceso a distintos ecosistemas de investigación.
Se trata de un equipo claramente multidisciplinar, formado por investigadores especializados en microbiología, biotecnología, bioprocesos y agronomía, que trabajan de manera integrada a lo largo de toda la cadena de valor, desde el aislamiento y la caracterización de microorganismos hasta el desarrollo de soluciones finales con aplicación real en campo.
Esta combinación de perfiles técnicos, junto con una estructura capaz de integrar conocimiento científico, regulatorio y agronómico, constituye la base que nos permite ejecutar una transferencia tecnológica eficaz y sostenible, asegurando que la innovación científica se traduzca en soluciones reales para el sector agrobiotecnológico.
El sector enfrenta retos enormes como el cambio climático y las restricciones regulatorias y administrativas ¿Cómo nos permite esta tecnología sobreponernos a los problemas que puedan surgir en el futuro de la agricultura?
Este enfoque basado en investigación básica y transferencia tecnológica permite, ante todo, realizar un uso mucho más eficiente de los recursos a la hora de seleccionar candidatos para proyectos futuros.
Disponer de una caracterización completa de posibles prototipos en fases muy tempranas de la investigación, facilita anticiparse tanto a problemas regulatorios como a limitaciones funcionales que, de no detectarse a tiempo, pueden obligar a descartar desarrollos en etapas avanzadas del proceso.
También, contar con esta información desde el inicio evita invertir tiempo y recursos en prototipos que difícilmente podrán llegar al mercado, permitiendo centrar los esfuerzos en aquellos con mayor viabilidad técnica, regulatoria y agronómica. De este modo, la toma de decisiones se vuelve más objetiva y estratégica, reduciendo riesgos a lo largo de toda la cadena de desarrollo.
En suma, un contexto marcado por el cambio climático y un marco regulatorio cada vez más exigente, este modelo permite seleccionar los mejores candidatos desde fases muy tempranas, optimizar los procesos de I+D y ganar una clara ventaja competitiva. Y como resultado, se tiene la capacidad de poner en el mercado soluciones más rápidas, más robustas y con todas las garantías necesarias para responder a los desafíos actuales y futuros de la agricultura.